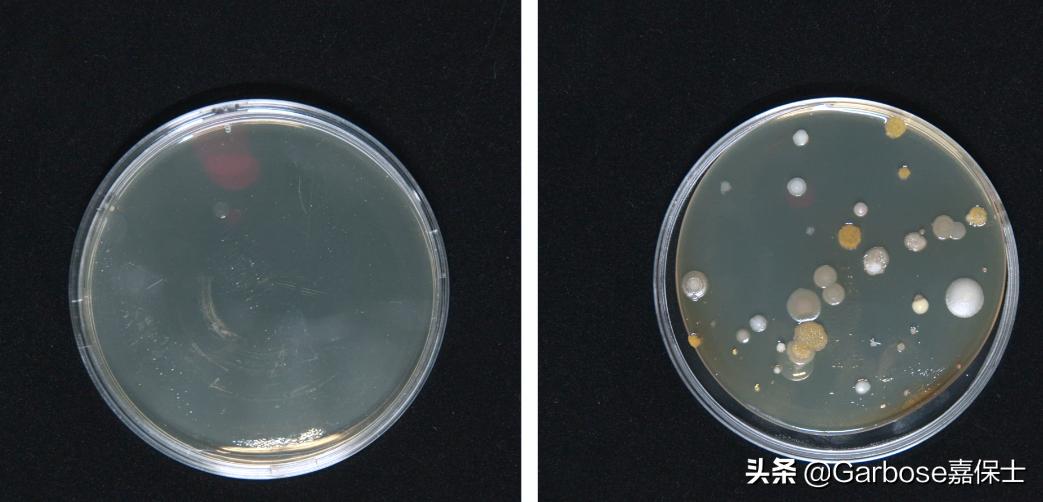
400平米空气净化器测评哪款最好,50元纳米科技空气净化器测评

空气净化器到底能达到什么样的效果,我们购买空净化器有多大作用,花几千元购买一台品质还不错的产品,进行测试,看看是否能满足我们日常需要的效果!如室内的甲醛、灰尘、颗粒物等,我们看看测评的结果能获得什么样的?

嘉保士GA01
这几年大众对室内的细菌和甲醛关注度比较高,那么我们可以从这里入手看看效果怎么样?
大多数病原体的体积都很大,其中一些是在水滴或气溶胶中“登上”的。直径一般为0.5~5μM,广泛应用于空气净化器中的HEPA型滤网等级为12或13级别,可过滤99.97%的0.3μM颗粒。

HEPA滤网
HEPA滤网可过滤直径大于20nm的微粒,包括细菌、霉菌、灰尘、过敏原和一些病毒。世界卫生组织出版物显示,禽流感、人流感病毒和军团菌均大于20纳米。
在室温下,无需任何能量,可达到除尘(99.97%)和杀菌(99.99%)的目的。0.1μm以上粉尘(烟、粉、尘等)的吸附率可达99.97%,对枯草杆菌具有很强的杀灭能力和较强的抑菌作用。
由此可见,空气净化器对病毒和细菌有一定的吸附过滤作用,让病毒和细菌无法逃逸。

这款空气净化器是综合产品,主要应对室内的甲醛、病毒和PM2.5,五层滤网+紫外线+负离子,层层滤除空气中的污染物。这是同类型产品无法比拟的效果,性价比高,因为是综合产品,因此作为测试效果更为佳!

除菌
这款空气净化器带有UV紫外线灯破坏细胞组织、裂解恶臭气体细菌病毒的分子键,使呈游离状态的污染物分子与臭氧氧化结合成无害小分子。过滤细菌高达≥99%。


让我们从今年我们最关心的“细菌”说起。空气中到处都是细菌。室内空气沉降法与室内空气沉降法比较。将空气净化器放入试验箱,开启空气净化器1小时。之后,将“无菌培养基”(大豆酪蛋白琼脂无菌培养基)置于实验箱内外,同时打开盖子。保存2小时后,取出放入恒温培养箱。
培养48小时后,结果能清晰地看到仓内外细菌数量的差异,净化器的过滤效果明显。

除甲醛
除了细菌,无形的甲醛可以说是空气中危害最大的污染物。现在购买空气净化器的消费者往往更注重产品的甲醛去除能力。将稀释后的福尔马林(甲醛水溶液)放入实验舱内,模拟室内甲醛污染源。同时将空气净化器和高精度甲醛检测仪放入试验箱,甲醛浓度趋于稳定。

净化可吸入颗粒物
当然,除了甲醛和细菌,净化空气中的可吸入颗粒物没有问题。在一立方米的实验舱内,模拟了香烟的重污染天气,并将数值控制在1000μg/m3以上。我们将空气净化器和颗粒物探测器放入试验箱,以确保试验过程中颗粒物的均匀性。
打开高档空气净化器进行极限测试。在实际测试中,座舱内的PM2.5值在47秒内降至10以下。
视频加载中...

这款嘉保士的空气净化器的颗粒物CADR值在488m³/h,建议使用面积58平米以下。此外,360°循环风管的设计也提高了室内空气循环速度,间接提高了整个房屋的净化效率。


这台净化器连接手机APP,应用程序可以直接调整模式以适应不同的生活场景,并可以实现定期预约。应用程序和机身上也会显示清晰的信息,以便及时了解室内空气质量、甲醛和过敏原。日常使用更符合中国人现在的习惯。

结合测试报告和我们的评测,这台空气净化器,它有良好的细菌水平,PM2.5,甲醛和过敏原。虽然国内室外空气环境正在逐步改善,但室内空气质量也非常值得关注。每增加新家具、新物品,都会带来室内空气污染的风险。因此,长期开放空气净化可以有效改善室内空气质量。当然,无论产品有多好,也不要忘了定期更换滤芯,打开窗户通风!